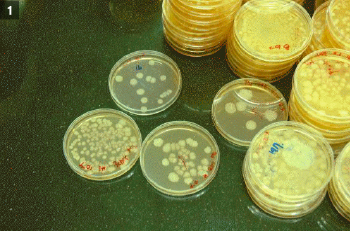

미생물 공학은
미생물을 이용하여 인간에게 유용한 여러 가지 물질을 생산하는 방법을 연구하는 학문입니다
-
사진1▲ Petri dish에서 분리 배양중인 각종 미생물
사진1▲ Petri dish에서 분리 배양중인 각종 미생물 -
 사진2▲ 탄소 전극에 부착된 전기 생성 미생물
사진2▲ 탄소 전극에 부착된 전기 생성 미생물 -
 사진3▲ 유용 물질 생산을 미생물 배양기. 현재 미생물 배양중
사진3▲ 유용 물질 생산을 미생물 배양기. 현재 미생물 배양중 -
 사진4▲ 2학년 학생을 위한 기본적인 교과서 중의 하나인 Brock의 미생물학
사진4▲ 2학년 학생을 위한 기본적인 교과서 중의 하나인 Brock의 미생물학
따라서 미생물 공학과에서는 미생물을 이용한 여러 유형, 무형의 유용물질의 (백신, 화장품, 항암제, 정밀화학제품, 발표식품, 생물소재 등)생산에 관련된 교육과 연구를 진행하고 있습니다.
-
 사진5▲ 바이오에너지 생산을 위한 조류 (algae) 생산실험
사진5▲ 바이오에너지 생산을 위한 조류 (algae) 생산실험 -
 사진6▲ 미생물 배양을 위한 배지 (medium) 제조
사진6▲ 미생물 배양을 위한 배지 (medium) 제조 -
 사진7▲ 미생물 배양 실험
사진7▲ 미생물 배양 실험 -
 사진8▲ DNA의 분리를 위한 전기영동 준비 중
사진8▲ DNA의 분리를 위한 전기영동 준비 중
-
 사진9▲ 조류배양 실험 준비중
사진9▲ 조류배양 실험 준비중 -
 사진10▲ HPLC (고성능 액체 크로마토그래피) 분석중
사진10▲ HPLC (고성능 액체 크로마토그래피) 분석중 -
 사진11▲ 미생물을 이용한 전기 생산 실험 (microbial fuel cell and biosensor) 준비중
사진11▲ 미생물을 이용한 전기 생산 실험 (microbial fuel cell and biosensor) 준비중 -
 사진12▲ 실험실에서 실험준비를 하고 있는 학생
사진12▲ 실험실에서 실험준비를 하고 있는 학생
학생의 입장에서, 미생물공학과에서의 생활은 이론적인 공부와, 토론과 스스로의 이해를 통하여 또 발표를 통하여 모르면 다시 물어보고, 토론하고 그리고 발표와 검증을 통하여 미생물의 세계를 하나하나 여러분 스스로의 것으로 만들어 나갑니다.
-
 사진13▲ 학회 참가를 위한 포스터 제작중
사진13▲ 학회 참가를 위한 포스터 제작중 -
 사진14▲ 시약장 앞을 지나는 학생
사진14▲ 시약장 앞을 지나는 학생 -
 사진15▲ 학생들이 실험 결과에 대하여 토론하고 있다
사진15▲ 학생들이 실험 결과에 대하여 토론하고 있다 -
 사진16▲ 학생들이 실험 결과에 대하여 토론하고 있다
사진16▲ 학생들이 실험 결과에 대하여 토론하고 있다
-

-
 사진18▲ 학생 세미나 진행중
사진18▲ 학생 세미나 진행중 -

-

미생물의 능력은 정말 탁월합니다. 약품도 만들고, 먹을 것도 만들고, 환경도 정화 시키고 심지어 전기도 냅니다.공부만 하느냐? 그건 아니죠. 체육대회도 하고 축제, MT, 발효식품도 만들고 외국 학회에 참가해서 발표도 하고...미국도 가고 태국도 가고 일본도 가고 또 시간 내서 폭포도 가 봅니다.
-

-

-
 사진▲23 미생물을 이용한 전기 생산 (microbial fuel cell)
사진▲23 미생물을 이용한 전기 생산 (microbial fuel cell) -
 사진▲24 2008 춘계 체육대회
사진▲24 2008 춘계 체육대회
-
 사진▲25 2008년 축제에서 미생물 공학과 발효식품 시음, 품평회겸..
사진▲25 2008년 축제에서 미생물 공학과 발효식품 시음, 품평회겸.. -
 사진▲26 Canada에서 열린 Biosensor 2006학회에서 윤석민군
사진▲26 Canada에서 열린 Biosensor 2006학회에서 윤석민군 -
 사진▲27 태국에서 개최된 생물공학회 참가 후
사진▲27 태국에서 개최된 생물공학회 참가 후 -
 사진▲28 일본 생물공학회에서 3개국어로 구두발표를 진행하는 권길광군
사진▲28 일본 생물공학회에서 3개국어로 구두발표를 진행하는 권길광군
-
 사진▲29 캐나다 학회 후 짬을 내어 방문한 Niagara Fall
사진▲29 캐나다 학회 후 짬을 내어 방문한 Niagara Fall -
 사진▲30 바이오에너지연구실
사진▲30 바이오에너지연구실
이렇게 미생물공학과에서의 생활을 마무리하면 많은 수의 학생들이 본교를 포함하는 전 세계 유명 대학 및 대학원에 보다 창의적이며 전문적인 연구를 위하여 진학하고 있으며, 졸업 후 세계 각국에서 교육과 연구를 활발하게 진행하고 있습니다.
생물공학 관련 기업

화장품 관련 기업

국공립 연구소

국내 외 제약회사

주류 및 식품 관련 기업

물론 계속 놀면 백수가 될지도 모릅니다...
이와는 별도로 다양한 전공 세부 분야에서 활약하시는 저명하고, 유능하고, 멋진 교수님이 많이 계시니, 대학원 과정을 통하여 심오한 미생물의 세계로 함께 여행을 떠날 수도 있습니다.
-

-
 사진▲32 한국백신-미생물공학과 취업 및 교육에 관한 산학협정 체결
사진▲32 한국백신-미생물공학과 취업 및 교육에 관한 산학협정 체결 -
 사진▲33 와인나라-미생물공학과 산업대학원 와인학과정 협력개설
사진▲33 와인나라-미생물공학과 산업대학원 와인학과정 협력개설 -

미생물 공학이 무엇인지 조금은 아시게 되었는지요? 질문이 있으시면 언제나 여러분의 선배나 학생회, 또 조교님, 교수님을 찾아주세요.
모쪼록 즐거운 그리고 유익하고 가치 있는 대학 생활이 되시길 기원합니다. 순간의 선택이 여러분의 일생을 좌우합니다.
미생물은 인간이 존재하는 마지막 순간 이후에도 존재합니다. 인류의 미래를 책임지는 건국대학교 미생물 공학과.
언제나 여러분과 함께합니다.
